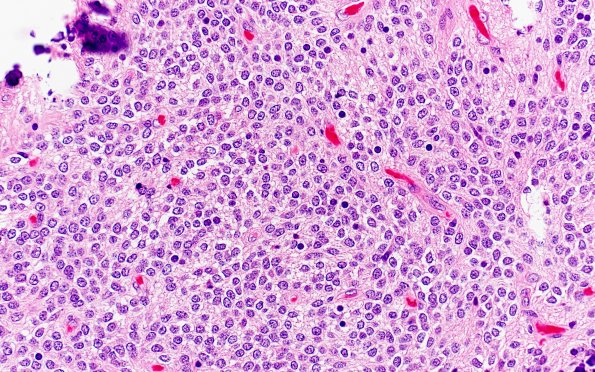
13B3 Central neurocytoma (Case 13) H&E 40X

Table of Contents
Washington University Experience | NEOPLASMS (NEURONAL) | Central Neurocytoma | 13B3 Central neurocytoma (Case 13) H&E 40X
H&E stained sections show a hypercellular neoplasm comprised of monotonous isomorphic sheets of tumor cells, demonstrating round-to-oval nuclei with smooth nuclear contours, fine chromatin and inconspicuous micronucleoli.